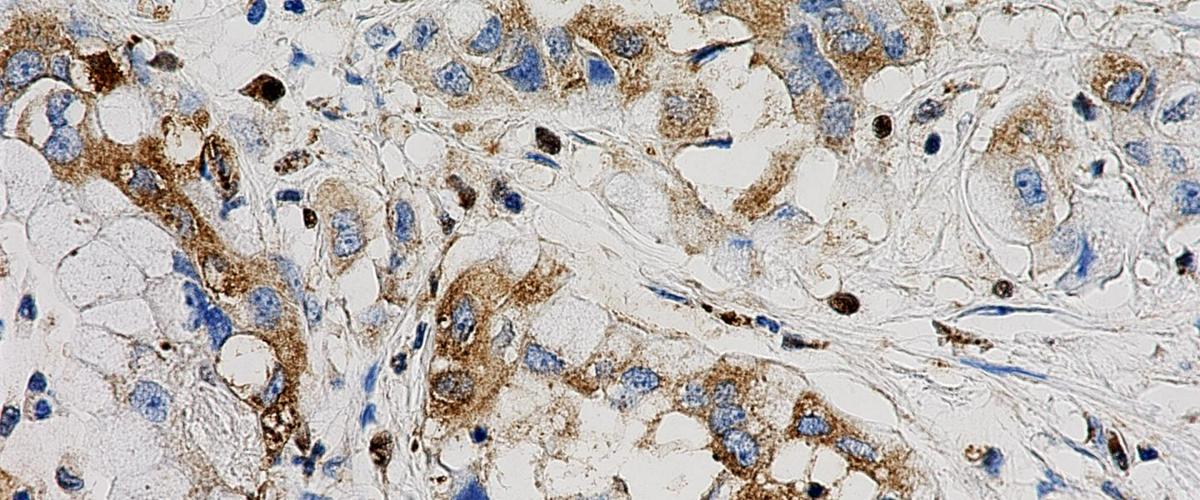
TODO:

Эксперименты ученых из Пенсильванского университета показали, что активация рецептора эстрогена GPER останавливает рост рака поджелудочной железы на моделях мышей и клеток человека. На протяжении десятилетий ученые знали, что существует связь между половыми гормонами и некоторыми типами рака. Новая работа, о которой рассказывает EurekAlert, показывает, что опухоли, локализующиеся вне репродуктивных тканей, также могут зависеть от их активности.
Активация GPER на разных моделях рака поджелудочной железы показала сильное ингибирование раковых клеток. Одновременно с этим опухолевые клетки становились более чувствительными к другим методам лечения рака. Например, опухолевые клетки оказались более видимыми для иммунной системы и, таким образом, более чувствительными к применению иммунотерапии.
«Активируя GPER, мы запускаем процессы, которые, вероятно, уже привычны для организма человека. Результаты доклинических экспериментов показывают, что побочные эффекты у человека, скорее всего, будут минимальными», — заявил первый автор исследования Кристофер Натале.
В настоящее время команда уже запустила первую фазу клинических исследований у пациентов с метастатическим раком поджелудочной железы.
Другой потенциальный вариант лечения опухоли поджелудочной железы предложили ученые из США. Их терапия направлена на активность аминокислоты в организме и также замедляет рост опухоли. Сегодня процент пятилетней выживаемости с этим диагнозом составляет лишь около 10%, поэтому успешные результаты тестирования новых препаратов дают надежду на улучшение качества лечения тысяч пациентов в будущем.